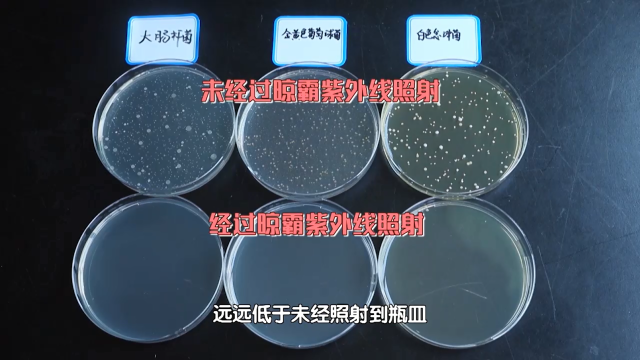

5月15日,由晾霸赞助的首档明星跨界家装改造真人纪实节目【向往的星居】,在北京卫视黄金档如期播出。备受期待的星居体验官金志文化身“宝藏DADDY”,用晾霸高端智能晾衣机,解锁阳台改造设计新技能。
跨界首秀|金志文遇到改造难题
星居体验官金志文和BTV主持人悦悦走进待改造业主家实地考察。
节目中,宝藏Daddy金志文初次挑战“星居体验官”,便遇到诸多改造难题。从改造手记可以看出……
“星居”改造的业主是三口之家,一家人的生活用品塞满整个空间,阳台区域也没有得到合理规划,还是在用传统的金属杆晾衣架,对于日常过来照顾金金的爷爷奶奶姥爷姥姥也特不方便。另外金金的公主裙和玩具公仔,因没有条件定时杀菌也面临卫生问题。
改造建议一:物品分区归纳
改造建议二:毛绒玩具要勤洗晾晒
高能解锁|设计师选择晾霸晾衣机
根据星居体验官金志文的改造建议,对于改造建议第二条:毛绒玩具要勤洗晾晒,设计师选择了晾霸高端智能晾衣机。同时,设计师顾浩也走进晾霸北京红星北五环店,亲身体验了一回。
顾浩走进晾霸北京红星北五环店
装了晾霸极光Q4声控除螨晾衣机,业主女儿的玩具娃娃们的卫生情况也就有了保证,女业主自然也不用担心女儿的健康了。
为了验证极光Q4声控除螨晾衣机的功能作用,节目也通过第三方实验室进行产品检测。
烘干功能实验
选择两件分别是21%和22%白衬衫进行实验对比,一件放到普通晾衣架自然晾干,另一件开启晾霸极光Q4进行烘干。
90分钟后自然晾干的衣服湿度为16.4%,而使用晾霸极光Q4声控除螨晾衣机烘干的衣服湿度仅为3.3%,烘干效果十分显著!
杀菌效果实验
节目组来到广州市微生物研究所进行检测。
在专业的实验室中,实验员将金黄色葡萄球菌、大肠杆菌、白色念球菌制成菌片,放到晾霸极光Q4声控除螨晾衣机上进行紫外线灯照射杀菌,另一组则不进行紫外线杀菌。
30分钟后,将样本送实验室进行活菌培养测试,可以明显看出,经过晾霸紫外线等照射后的菌片,其金黄色葡萄球菌、大肠杆菌、白色念球菌远远低于未经照射的菌片。
有了晾霸极光Q4声控除螨晾衣机,业主夫妻可以放心让女儿和自己心爱的巴啦啦小魔仙、爱莎公主、叶罗丽等毛绒玩具们亲密接触了。
完美收房|晾霸智能晾衣机太了不起
改造升级后的阳台,使用晾霸极光Q4声控除螨晾衣机,为业主一家带来了了不起的亮点和惊喜。
1、晾霸极光Q4是可以通过声控的AI智能晾衣机;
2、汇集风干、烘干、杀菌、除螨等功能;
3、梦幻粉机身颜色,小宝贝们超喜欢。
改造前:
空间凌乱,视觉特不舒服;低端没档次;不能升降;没风干、烘干、杀菌、除螨等功能。
改造后:
空间一下子变得舒服很多;高大上;智能升降;汇集智能风干、烘干、杀菌、除螨、AI语音控制功能。
晾霸极光Q4声控除螨晾衣机这款能自动升降的晾衣机,解决了业主夫妻晾晒衣物的难题,尤其对小女儿金金的公主裙和玩具更起到杀菌除螨作用,这样妈妈以后就能放心地让金金玩玩具了!
设计有爱,家就有光。星居体验官金志文和设计师的改造方案,让业主全家感到非常满意。
节目的结尾,金志文表示:在为业主家庭装修的过程中,也多了些跟女儿相处的机会。现在,他可能找到一些做父亲的感觉了,知道作为一名父亲该做些什么,陪伴就是最好的父爱。
晾霸也希望通过自己的产品和服务,为万千家庭创造更好的生活品质和体验,让更多像智能晾衣机这样有爱的设计和产品,为家人带来更多陪伴。
凡本网注明“出处:其他”的内容,均转载自其它媒体,转载目的在于传递更多信息,并不代表本网赞同其观点和对其真实性负责。 如有侵权及时联系本网站,本网将在第一时间删除!转载内容的准确性由原内容提供者独立承担完全责任!


佚名
2019-5-17 18:14:21